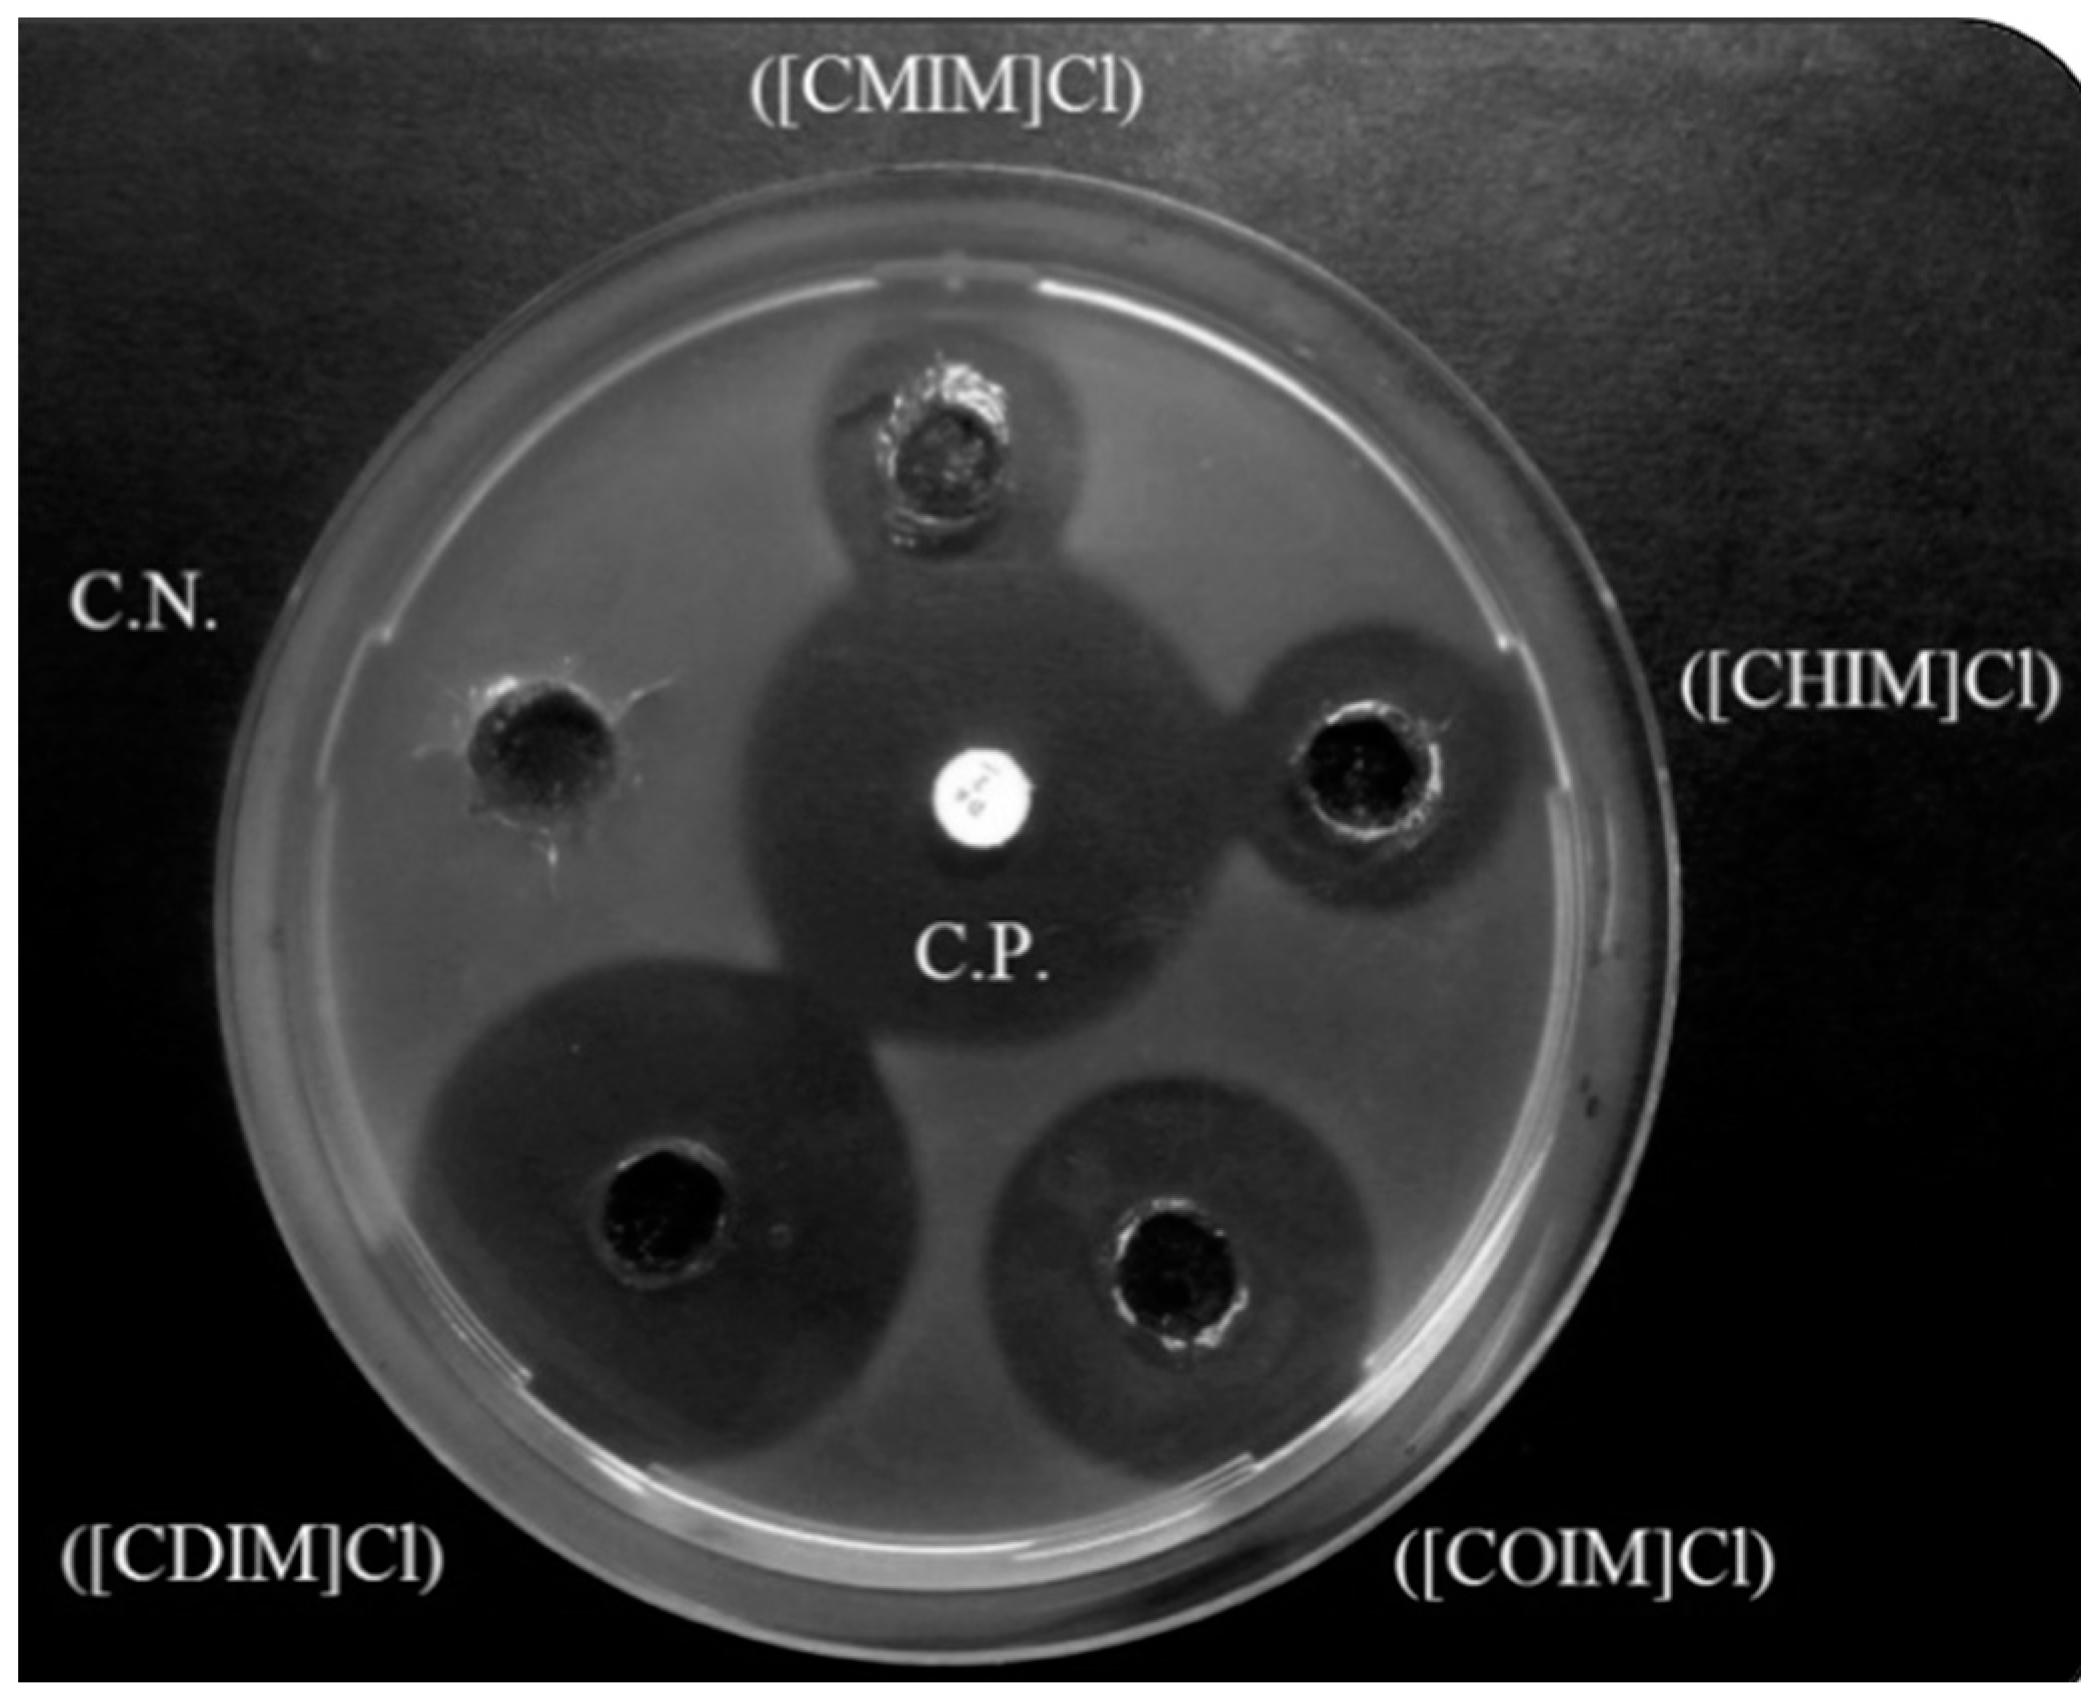

Novel Alkylimidazolium Ionic Liquids as an Antibacterial Alternative to Pathogens of the Skin and Soft Tissue Infections
Abstract
1. Introduction
2. Results
2.1. Chemistry
2.2. Fourier-Transform Infrared Spectroscopy (FT-IR)
2.3. Thermal Stability
2.4. Antibacterial Screening
2.5. Determination of Minimum Inhibitory Concentration (MIC) and Mean Inhibition of Bacterial Viability (IC50)
2.6. Molecular Dynamics Simulations (MDs) and ADME Properties
3. Discussion
4. Material and Methods
4.1. General Information
4.2. Chemistry
4.2.1. General Procedure for Alkylimidazoles Synthesis
4.2.2. General Procedure for the Construction of Different N-Cinnamylimidazolium Ionic Liquids
4.3. Growth Conditions and Strains
4.4. Antibacterial Screening
4.5. Determination of Minimum Inhibitory Concentration (MIC) and Half Maximum Inhibitory Concentration (IC50) by 96-Well Plate Microdilution
4.6. Molecular Dynamics Simulations (MDs)
4.7. ADME Properties Prediction
5. Conclusions
Supplementary Materials
Author Contributions
Funding
Acknowledgments
Conflicts of Interest
References
- Esposito, S.; Bassetti, M.; Bonnet, E.; Bouza, E.; Chan, M.; De Simone, G.; Dryden, M.; Gould, I.; Lye, D.C.; Saeed, K.; et al. Hot topics in the diagnosis and management of skin and soft-tissue infections. Int. J. Antimicrob. Agents 2016, 48, 19–26. [Google Scholar] [CrossRef] [PubMed]
- Moffarah, A.; Al Mohajer, M.; Hurwitz, B.; Armstrong, D. Skin and soft tissue infections. Microbiol. Spectrum 2016, 4, 16. [Google Scholar]
- Robineau, O.; Nguyen, S.; Senneville, E. Optimising the quality and outcomes of treatments for diabetic foot infections. Expert Rev. Anti-Infect. Ther. 2016, 14, 817–827. [Google Scholar] [CrossRef] [PubMed]
- Hackel, M.; Kazmierczak, K.M.; Hoban, D.J.; Biedenbach, D.J.; Bouchillon, S.K.; de Jonge, B.L.; Stone, G.G. Assessment of the in vitro activity of ceftazidime-avibactam against multidrug-resistant Klebsiella spp. Collected in the inform global surveillance study, 2012 to 2014. Antimicrob. Agents Chemother. 2016, 60, 4677–4683. [Google Scholar] [CrossRef] [PubMed]
- Prestinaci, F.; Pezzotti, P.; Pantosti, A. Antimicrobial resistance: A global multifaceted phenomenon. Pathog. Glob. Health 2015, 109, 309–318. [Google Scholar] [CrossRef] [PubMed]
- Guibal, E.; Vincent, T.; Jouannin, C. Immobilization of extractants in biopolymer capsules for the synthesis of new resins: A focus on the encapsulation of tetraalkyl phosphonium ionic liquids. J. Mater. Chem. 2009, 19, 8515–8527. [Google Scholar] [CrossRef]
- Bahrami, K.; Saleh, S. [BTBA]Cl-FeCl3 as an efficient lewis acid ionic liquid for the synthesis of perimidine derivatives. Synth. React. Inorg. Met.-Org. Chem. 2016, 46, 852–856. [Google Scholar] [CrossRef]
- Sivapragasam, M.; Moniruzzaman, M.; Goto, M. Recent advances in exploiting ionic liquids for biomolecules: Solubility, stability and applications. Biotechnol. J. 2016, 11, 1000–1013. [Google Scholar] [CrossRef] [PubMed]
- Seddon, K.R.; Stark, A.; Torres, M.J. Influence of chloride, water, and organic solvents on the physical properties of ionic liquids. Pure Appl. Chem. 2000, 72, 2275. [Google Scholar] [CrossRef]
- Coleman, D.; Gathergood, N. Biodegradation studies of ionic liquids. Chem. Soc. Rev. 2010, 39, 600–637. [Google Scholar] [CrossRef] [PubMed]
- Jordan, A.; Gathergood, N. Biodegradation of ionic liquids—A critical review. Chem. Soc. Rev. 2015, 44, 8200–8237. [Google Scholar] [CrossRef] [PubMed]
- Aher, S.; Bhagat, P. Convenient synthesis of imidazolium based dicationic ionic liquids. Res. Chem. Intermed. 2016, 42, 5587–5596. [Google Scholar] [CrossRef]
- Draye, M.; Kardos, N. Advances in green organic sonochemistry. Top. Curr. Chem. 2016, 374, 74. [Google Scholar] [CrossRef] [PubMed]
- Patil, S.A.; Patil, R. Microwave-assisted synthesis of chromenes: Biological and chemical importance. Future Med. Chem. 2015, 7, 893–909. [Google Scholar] [CrossRef] [PubMed]
- Tarasova, N.; Zanin, A.; Burdakov, K.; Sobolev, P. Ionic liquids and microwave irradiation in polymer synthesis: Ionic liquids and microwave irradiation in polymer synthesis. Polym. Adv. Technol. 2015, 26, 687–695. [Google Scholar] [CrossRef]
- Awad, W.H.; Gilman, J.W.; Nyden, M.; Harris, R.H.; Sutto, T.E.; Callahan, J.; Trulove, P.C.; DeLong, H.C.; Fox, D.M. Thermal degradation studies of alkyl-imidazolium salts and their application in nanocomposites. Thermochim. Acta 2004, 409, 3–11. [Google Scholar] [CrossRef]
- Ding, Y.S.; Zha, M.; Zhang, J.; Wang, S.S. Synthesis of a kind of geminal imidazolium ionic liquid with long aliphatic chains. Chin. Chem. Lett. 2007, 18, 48–50. [Google Scholar] [CrossRef]
- Ding, Y.-S.; Zha, M.; Zhang, J.; Wang, S.-S. Synthesis, characterization and properties of geminal imidazolium ionic liquids. Colloids Surf. A Physicochem. Eng. Aspects 2007, 298, 201–205. [Google Scholar] [CrossRef]
- Singh, K.D.; Kirubakaran, P.; Nagarajan, S.; Sakkiah, S.; Muthusamy, K.; Velmurgan, D.; Jeyakanthan, J. Homology modeling, molecular dynamics, e-pharmacophore mapping and docking study of chikungunya virus nsp2 protease. J. Mol. Model. 2012, 18, 39–51. [Google Scholar] [CrossRef] [PubMed]
- Erdmenger, T.; Vitz, J.; Wiesbrock, F.; Schubert, U.S. Influence of different branched alkyl side chains on the properties of imidazolium-based ionic liquids. J. Mater. Chem. 2008, 18, 5267–5273. [Google Scholar] [CrossRef]
- Anderson, J.L.; Ding, R.; Ellern, A.; Armstrong, D.W. Structure and properties of high stability geminal dicationic ionic liquids. JACS 2005, 127, 593–604. [Google Scholar] [CrossRef] [PubMed]
- Al-Mohammed, N.N.; Alias, Y.; Abdullah, Z. Bis-imidazolium and benzimidazolium based gemini-type ionic liquids structure: Synthesis and antibacterial evaluation. RSC Adv. 2015, 5, 92602–92617. [Google Scholar] [CrossRef]
- Palchowdhury, S.; Bhargava, B.L. Effect of spacer chain length on the liquid structure of aqueous dicationic ionic liquid solutions: Molecular dynamics studies. PCCP 2015, 17, 11627–11637. [Google Scholar] [CrossRef] [PubMed]
- Tröger-Müller, S.; Brandt, J.; Antonietti, M.; Liedel, C. Green imidazolium ionics—from truly sustainable reagents to highly functional ionic liquids. Chemistry 2017, 23, 11810–11817. [Google Scholar] [CrossRef] [PubMed]
- Anvari, S.; Hajfarajollah, H.; Mokhtarani, B.; Enayati, M.; Sharifi, A.; Mirzaei, M. Antibacterial and anti-adhesive properties of ionic liquids with various cationic and anionic heads toward pathogenic bacteria. J. Mol. Liq. 2016, 221, 685–690. [Google Scholar] [CrossRef]
- Busetti, A.; Crawford, D.E.; Earle, M.J.; Gilea, M.A.; Gilmore, B.F.; Gorman, S.P.; Laverty, G.; Lowry, A.F.; McLaughlin, M.; Seddon, K.R. Antimicrobial and antibiofilm activities of 1-alkylquinolinium bromide ionic liquids. Green Chem. 2010, 12, 420–425. [Google Scholar] [CrossRef]
- Cornellas, A.; Perez, L.; Comelles, F.; Ribosa, I.; Manresa, A.; Garcia, M.T. Self-aggregation and antimicrobial activity of imidazolium and pyridinium based ionic liquids in aqueous solution. J. Colloid Interface Sci. 2011, 355, 164–171. [Google Scholar] [CrossRef] [PubMed]
- Luczak, J.; Jungnickel, C.; Lacka, I.; Stolte, S.; Hupka, J. Antimicrobial and surface activity of 1-alkyl-3-methylimidazolium derivatives. Green Chem. 2010, 12, 593–601. [Google Scholar] [CrossRef]
- Ferraz, R.; Teixeira, V.; Rodrigues, D.; Fernandes, R.; Prudencio, C.; Noronha, J.P.; Petrovski, Z.; Branco, L.C. Antibacterial activity of ionic liquids based on ampicillin against resistant bacteria. RSC Adv. 2014, 4, 4301–4307. [Google Scholar] [CrossRef]
- Pernak, J.; Smiglak, M.; Griffin, S.T.; Hough, W.L.; Wilson, T.B.; Pernak, A.; Zabielska-Matejuk, J.; Fojutowski, A.; Kita, K.; Rogers, R.D. Long alkyl chain quaternary ammonium-based ionic liquids and potential applications. Green Chem. 2006, 8, 798–806. [Google Scholar] [CrossRef]
- Patel, R.; Kumari, M.; Khan, A.B. Recent advances in the applications of ionic liquids in protein stability and activity: A review. Appl. Biochem. Biotechnol. 2014, 172, 3701–3720. [Google Scholar] [CrossRef] [PubMed]
- Saadeh, S.M.; Yasseen, Z.; Sharif, F.A.; Abu Shawish, H.M. New room temperature ionic liquids with interesting ecotoxicological and antimicrobial properties. Ecotoxicol. Environ. Saf. 2009, 72, 1805–1809. [Google Scholar] [CrossRef] [PubMed]
- Hajfarajollah, H.; Mokhtarani, B.; Noghabi, K.A.; Sharifi, A.; Mirzaei, M. Antibacterial and antiadhesive properties of butyl-methylimidazolium ionic liquids toward pathogenic bacteria. RSC Adv. 2014, 4, 42751–42757. [Google Scholar] [CrossRef]
- Villablanca, M.; Zenelman, R.; Montoya, R. Plasmid-mediated resistance towards aminoglycoside antibiotics in some strains of gram-negative bacilli. Exp. Biol. Med. 1982, 15, R176. [Google Scholar]
- Logan, L.K.; Weinstein, R.A. The epidemiology of carbapenem-resistant enterobacteriaceae: The impact and evolution of a global menace. J. Infect. Dis. 2017, 215, S283–S286. [Google Scholar] [CrossRef] [PubMed]
- Ramaswamy, V.K.; Cacciotto, P.; Malloci, G.; Vargiu, A.V.; Ruggerone, P. Computational modelling of efflux pumps and their inhibitors. Essays Biochem. 2017, 61, 141–156. [Google Scholar] [CrossRef] [PubMed]
- Bernot, R.J.; Brueseke, M.A.; Evans-White, M.A.; Lamberti, G.A. Acute and chronic toxicity of imidazolium-based ionic liquids on daphnia magna. Environ. Toxicol. Chem. 2009, 24, 87–92. [Google Scholar] [CrossRef]
- Diaz, E.; Monsalvo, V.M.; Lopez, J.; Mena, I.F.; Palomar, J.; Rodriguez, J.J.; Mohedano, A.F. Assessment the ecotoxicity and inhibition of imidazolium ionic liquids by respiration inhibition assays. Ecotoxicol. Environ. Saf. 2018, 162, 29–34. [Google Scholar] [CrossRef] [PubMed]
- Shao, Y.; Wang, J.; Du, Z.; Li, B.; Zhu, L. Toxicity of 1-alkyl-3-methyl imidazolium nitrate ionic liquids to earthworms: The effects of carbon chains of different lengths. Chemosphere 2018, 206, 302–309. [Google Scholar] [CrossRef] [PubMed]
- Santos, Á.; Soares, J.X.; Cravo, S.; Tiritan, M.E.; Reis, S.; Afonso, C.; Fernandes, C.; Pinto, M.M. Lipophilicity assessement in drug discovery: Experimental and theoretical methods applied to xanthone derivatives. J. Chromatogr. B 2018, 1072, 182–192. [Google Scholar] [CrossRef] [PubMed]
- Biemer, J.J. Antimicrobial susceptibility testing by the Kirby-Bauer disc diffusion method. Ann. Clin. Lab. Sci. 1973, 3, 135–140. [Google Scholar] [PubMed]
- Eloff, J.N. A sensitive and quick microplate method to determine the minimal inhibitory concentration of plant extracts for bacteria. Planta Med. 1998, 64, 711–713. [Google Scholar] [CrossRef] [PubMed]
- Neria, E.; Fischer, S.; Karplus, M. Simulation of activation free energies in molecular systems. J. Chem. Phys. 1996, 105, 1902–1921. [Google Scholar] [CrossRef]
- Vanommeslaeghe, K.; Hatcher, E.; Acharya, C.; Kundu, S.; Zhong, S.; Shim, J.; Darian, E.; Guvench, O.; Lopes, P.; Vorobyov, I.; et al. CHARMM general force field: A force field for drug-like molecules compatible with the CHARMM all-atom additive biological force fields. J. Comput. Chem. 2010, 31, 671–690. [Google Scholar] [CrossRef] [PubMed]
- Phillips, J.C.; Braun, R.; Wang, W.; Gumbart, J.; Tajkhorshid, E.; Villa, E.; Chipot, C.; Skeel, R.D.; Kalé, L.; Schulten, K. Scalable molecular dynamics with NAMD. J. Comput. Chem. 2005, 26, 1781–1802. [Google Scholar] [CrossRef] [PubMed]
- Vanommeslaeghe, K.; Raman, E.P.; MacKerell, A.D. Automation of the CHARMM General Force Field (CGenFF) II: Assignment of Bonded Parameters and Partial Atomic Charges. J. Chem. Inf. Model. 2012, 52, 3155–3168. [Google Scholar] [CrossRef] [PubMed]
- Humphrey, W.; Dalke, A.; Schulten, K. Vmd: Visual molecular dynamics. J. Mol. Graph. 1996, 14, 33–38. [Google Scholar] [CrossRef]
- Caporuscio, F.; Rastelli, G.; Imbriano, C.; Del Rio, A. Structure-based design of potent aromatase inhibitors by high-throughput docking. J. Med. Chem. 2011, 54, 4006–4017. [Google Scholar] [CrossRef] [PubMed]
- Lipinski, C.A.; Lombardo, F.; Dominy, B.W.; Feeney, P.J. Experimental and computational approaches to estimate solubility and permeability in drug discovery and development settings. Adv. Drug Deliv. Rev. 2001, 46, 3–26. [Google Scholar] [CrossRef]
Sample Availability: Samples of the compounds are not available from the authors. |

| Ionic Liquids | Temperature (°C) Corresponding to | ||
|---|---|---|---|
| Tonset/°C a | T10/°C b | T50/°C c | |
| [CMIM]Cl | 61 | 118 | 245 |
| [CHIM]Cl | 76 | 148 | 251 |
| [COIM]Cl | 91 | 176 | 251 |
| [CDIM]Cl | 106 | 193 | 257 |
| Gram-Positive Bacteria | |||||||||||||||
| S. aureus | S. pyogenes | S. epidermidis | |||||||||||||
| mM | 0.125 | 0.25 | 0.5 | 1 | 2 | 0.125 | 0.25 | 0.5 | 1 | 2 | 0.125 | 0.25 | 0.5 | 1 | 2 |
| Imidazole | − | − | − | − | − | − | − | − | − | − | − | − | − | − | − |
| [CMIM]Cl | − | − | + | ++ | ++ | − | + | ++ | ++ | ++ | − | − | + | ++ | ++ |
| [CHIM]Cl | − | − | ++ | ++ | ++ | − | ++ | ++ | ++ | ++ | − | − | ++ | ++ | ++ |
| [COIM]Cl | − | ++ | ++ | ++ | ++ | − | ++ | ++ | ++ | ++ | + | ++ | ++ | ++ | ++ |
| [CDIM]Cl | − | ++ | ++ | ++ | +++ | − | ++ | ++ | ++ | +++ | ++ | ++ | ++ | ++ | ++ |
| Gram-Negative Bacteria | |||||||||||||||
| E. coli | P. aeruginosa | A. baumannii | |||||||||||||
| mM | 0.125 | 0.25 | 0.5 | 1 | 2 | 0.125 | 0.25 | 0.5 | 1 | 2 | 0.125 | 0.25 | 0.5 | 1 | 2 |
| Imidazole | − | − | − | − | − | − | − | − | - | − | − | − | − | − | − |
| [CMIM]Cl | − | − | − | − | ++ | − | − | − | - | − | − | − | − | − | + |
| [CHIM]Cl | − | − | ++ | ++ | ++ | − | − | − | − | − | − | − | − | − | + |
| [COIM]Cl | − | − | ++ | ++ | ++ | − | − | − | − | − | − | − | − | + | ++ |
| [CDIM]Cl | − | − | ++ | ++ | ++ | − | − | − | − | − | − | − | − | ++ | ++ |
| MIC (μM) | ||||
| [CMIM]Cl | [CHIM]Cl | [COIM]Cl | [CDIM]Cl | |
| S. aureus | 250 | 125 | 62.5 | 31.25 |
| S. pyogenes | 125 | 62.5 | 62.5 | 31.25 |
| S. epidermidis | 250 | 125 | 62.5 | 31.25 |
| E. coli | 2000 | 500 | 500 | 250 |
| P. aeruginosa | >2000 | > 2000 | > 2000 | > 2000 |
| A. baumannii | 2000 | 1000 | 1000 | 1000 |
| IC50 (μM) | ||||
| [CMIM]Cl | [CHIM]Cl | [COIM]Cl | [CDIM]Cl | |
| S. aureus | 137 | 106 | 32.9 | 27.3 |
| S. pyogenes | 41.6 | 38.1 | 25 | 19.4 |
| S. epidermidis | 149 | 55.7 | 38.5 | 31.2 |
| E. coli | 1380 | 340 | 290 | 210 |
| P. aeruginosa | >2000 | >2000 | >2000 | >2000 |
| A. baumannii | 1870 | 570 | 480 | 465 |
| Ligands | MW (g/mol) a | HB-D b | HB-A c | Rotable Bonds | Total SASA d | MV (Å3) e | PSA f |
|---|---|---|---|---|---|---|---|
| [CMIM]Cl | 200.283 | 0 | 4 | 3 | 491.174 | 799.137 | 5.203 |
| [CHIM]Cl | 270.417 | 0 | 4 | 8 | 587.938 | 1055.386 | 4.991 |
| [COIM]Cl | 298.470 | 0 | 4 | 10 | 607.754 | 1137.921 | 4.991 |
| [CDIM]Cl | 326.524 | 0 | 4 | 12 | 630.815 | 1217.397 | 4.991 |
| Lead Ligands | QP log P (o/w) a | QP log S b | QP log HERG c | QP log Kp d | % HOA in GI e | Qual HOA Model f | Lipinski’s Rule of 5 Violations g |
|---|---|---|---|---|---|---|---|
| [CMIM]Cl | 1.859 | −0.503 | −6.903 | −4.295 | 88 | HIGH | 0 |
| [CHIM]Cl | 3.511 | −1.523 | −6.728 | −3.877 | 100 | HIGH | 0 |
| [COIM]Cl | 4.028 | −1.573 | −6.404 | −3.748 | 100 | HIGH | 0 |
| [CDIM]Cl | 4.523 | −1.684 | −6.197 | −3.628 | 100 | HIGH | 0 |
© 2018 by the authors. Licensee MDPI, Basel, Switzerland. This article is an open access article distributed under the terms and conditions of the Creative Commons Attribution (CC BY) license (http://creativecommons.org/licenses/by/4.0/).
Share and Cite
Forero Doria, O.; Castro, R.; Gutierrez, M.; Gonzalez Valenzuela, D.; Santos, L.; Ramirez, D.; Guzman, L. Novel Alkylimidazolium Ionic Liquids as an Antibacterial Alternative to Pathogens of the Skin and Soft Tissue Infections. Molecules 2018, 23, 2354. https://doi.org/10.3390/molecules23092354
Forero Doria O, Castro R, Gutierrez M, Gonzalez Valenzuela D, Santos L, Ramirez D, Guzman L. Novel Alkylimidazolium Ionic Liquids as an Antibacterial Alternative to Pathogens of the Skin and Soft Tissue Infections. Molecules. 2018; 23(9):2354. https://doi.org/10.3390/molecules23092354
Chicago/Turabian StyleForero Doria, Oscar, Ricardo Castro, Margarita Gutierrez, Diego Gonzalez Valenzuela, Leonardo Santos, David Ramirez, and Luis Guzman. 2018. "Novel Alkylimidazolium Ionic Liquids as an Antibacterial Alternative to Pathogens of the Skin and Soft Tissue Infections" Molecules 23, no. 9: 2354. https://doi.org/10.3390/molecules23092354
APA StyleForero Doria, O., Castro, R., Gutierrez, M., Gonzalez Valenzuela, D., Santos, L., Ramirez, D., & Guzman, L. (2018). Novel Alkylimidazolium Ionic Liquids as an Antibacterial Alternative to Pathogens of the Skin and Soft Tissue Infections. Molecules, 23(9), 2354. https://doi.org/10.3390/molecules23092354

